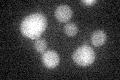
YDL076C
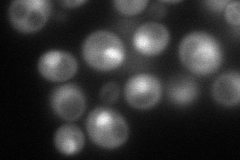
YDL076C
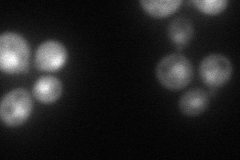
YDL076C
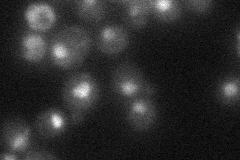
YDL076C
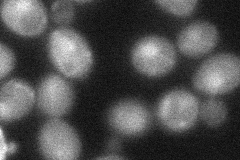
YDL076C
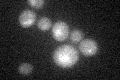
YDL076C

View description
Subunit of the RPD3L complex; involved in histone deacetylation
Localization:
Intensity:
Fold change:
Significance:
-
C’ GFP library in SD
below threshold17.11 -
N' NOP1pr-GFP in SD
nucleus106.675 -
N' TEF2pr-mCherry in SD
nucleus84.2121 -
N' NATIVEpr-GFP in SD
nucleus33.696 -
N' TEF2pr-VC and Cyto-VN in SD
nucleus41.6533 -
C’ GFP library in SD+DTT
cytosol17.911.04No -
C’ GFP library in SD+H2O2

cytosol18.511.08No -
C’ GFP library in Starvation Media

cytosol17.131No -
C’ GFP library on the background of Pup2-DaMP

below threshold -
C’ GFP library on the background of CCT mutant

below threshold17.65031.03137No
